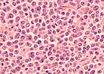

Lymphoma trial finds combination targeted therapy effective prior to chemotherapy
ScienceDaily | Jun 07, 2019
Patterns of chronic lymphocytic leukemia growth identified
Newswise | Jun 01, 2019
Toward a safer treatment for leukemia
MedicalXpress Breaking News-and-Events | Jun 01, 2019
New evidence supports surgery for rare type of brain lymphoma
Newswise | May 30, 2019
Researchers pinpoint why lymphoma patients may become resistant to specific therapy
MedicalXpress Breaking News-and-Events | May 18, 2019
Potential targeted treatment for acute myeloid leukemia identified
Newswise | May 17, 2019
Why Hodgkin's lymphoma cells grow uncontrollably
ScienceDaily | May 16, 2019
New cancer therapy target found in mitochondria for potential treatment of blood cancers
Newswise | May 06, 2019
Radiotherapy after chemo may improve survival in patients with advanced Hodgkin's lymphoma
ScienceDaily | May 02, 2019
Two birds, one stone - drug combination may prove effective against a second type of leukemia
Newswise | Apr 30, 2019